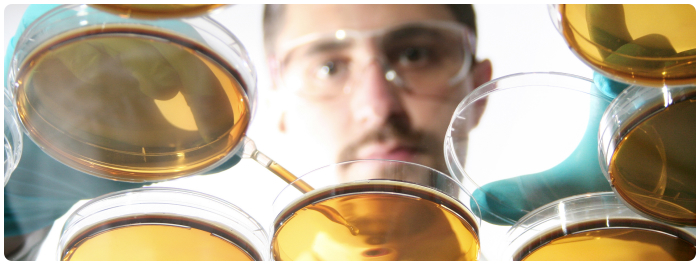

การตรวจอุจจาระ (Stool examination)
- โดย ศาสตราจารย์เกียรติคุณ แพทย์หญิง พวงทอง ไกรพิบูลย์
- 29 ตุลาคม 2565
- Tweet
สารบัญ
- บทนำ: คืออะไร?
- การตรวจอุจจาระมีประโยชน์อย่างไร?
- ข้อบ่งชี้การตรวจอุจจาระมีอะไรบ้าง?
- ข้อห้ามการตรวจอุจจาระมีอะไรบ้าง?
- การตรวจอุจจาระตรวจอะไรบ้าง?
- เตรียมตัวอย่างไรในการตรวจอุจจาระ?
- มีขั้นตอนการตรวจอุจจาระอย่างไร?
- ได้ผลตรวจเมื่อไร?
- แปลผลตรวจอุจจาระอย่างไร?
- การตรวจอุจจาระมีผลข้างเคียงไหม?
- หลังตรวจต้องปฏิบัติตนอย่างไร?
- บรรณานุกรม
บทความที่เกี่ยวข้อง
- กายวิภาคและสรีรวิทยาระบบทางเดินอาหาร (Anatomy and physiology of alimentary system)
- โลหิตจาง เลือดจาง ซีด (Anemia)
- ท้องเสีย ท้องร่วง ท้องเดิน (Diarrhea)
- สัตว์เซลล์เดียว โรคติดเชื้อสัตว์เซลล์เดียว โรคติดเชื้อโปรโทซัว (Protozoan infection)
- โรคติดเชื้อปรสิต (Parasitic infection)
- ลำไส้อักเสบ (Enterocolitis)
- ลำไส้ใหญ่อักเสบ (Colitis)
- เลือดออกในทางเดินอาหาร (Gastrointestinal bleeding or GI bleeding)
บทนำ: คืออะไร?
การตรวจอุจจาระ (Stool examination หรือ Stool test หรือ Stool analysis) คือ การตรวจสุขภาพพื้นฐานการตรวจหนึ่ง เพื่อช่วยแพทย์ในการวินิจฉัยความผิดปกติ หรือโรคในระบบทางเดินอาหาร, หรือหาสาเหตุภาวะ/โรคซีด โดยเป็นการตรวจลักษณะอุจจาระด้วยตาเปล่า ร่วมกับการตรวจด้วยกล้องจุลทรรศน์ และการตรวจทางห้องปฏิบัติการ
การตรวจอุจจาระ เป็นการตรวจที่ง่าย ขั้นตอนการตรวจไม่ยุ่งยาก ไม่เจ็บตัว ไม่ต้องใช้เทคโนโลยีสูง จึงสามารถให้บริการได้ตั้งแต่ในคลินิก, ในสถานพยาบาลขนาดเล็ก, ไปจนถึงในโรงพยาบาลทุกระดับ, นอกจากนี้ ค่าใช้จ่ายในการตรวจยังไม่แพง และสามารถช่วยวินิจฉัยโรคพื้นฐานในระบบทางเดินอาหารได้หลายโรค เช่น ภาวะ/อาการอาหารไม่ย่อย, โรคพยาธิต่างๆของระบบทางเดินอาหาร, และสามารถตรวจได้ในคนทุกเพศและทุกวัย ตั้งแต่เด็กแรกเกิด(นิยามคำว่าเด็ก)ไปจนถึงผู้สูงอายุ, ดังนั้นจึงเหมาะที่จะเป็นการตรวจสุขภาพพื้นฐานประจำปีของทุกๆคน
การตรวจอุจจาระมีประโยชน์อย่างไร?
ประโยชน์ของการตรวจอุจจาระ: เช่น
- ตรวจสุขภาพระบบทางเดินอาหาร เช่น ของกระเพาะอาหาร และ/หรือลำไส้
- ตรวจหาตัวพยาธิและไข่พยาธิในระบบทางเดินอาหาร เช่น พยาธิเส้นด้าย, ฯลฯ
- ตรวจเพาะเชื้อว่า โรคทางเดินอาหารนั้นๆเกิดจากติดเชื้อหรือไม่ฯ และเชื้ออะไรฯ (แบคทีเรีย โรคติดเชื้อไวรัส โรคเชื้อรา หรือ โรคติดเชื้อปรสิต) เช่น กรณีท้องเสียโดยเฉพาะท้องเสียเป็นๆหายๆ/เรื้อรัง หรือ อาหารเป็นพิษ
- ตรวจระบบการย่อย, การดูดซึมอาหาร, ของกระเพาะอาหารและลำไส้
- ตรวจการมีแผลเรื้อรังในทางเดินอาหารที่ก่ออาการเลือดออกเรื้อรัง เช่น แผลในกระเพาะอาหาร/แผลเปบติค หรือแผลโรคมะเร็งในทางเดินอาหาร เช่น โรคมะเร็งลำไส้ใหญ่
ข้อบ่งชี้การตรวจอุจจาระมีอะไรบ้าง?
ข้อบ่งชี้ในการตรวจอุจจาระ: เช่น
- เป็นการตรวจสุขภาพประจำปี เพื่อดูสุขภาพทั่วไปของระบบทางเดินอาหาร เช่น อาจ มีไข่พยาธิเพราะหลายคนมีพยาธิโดยไม่รู้ตัว คือไม่มีอาการ, ตรวจความผิดปกติ อื่นๆ เช่น อุจจาระมีไขมันปนมากที่เป็นตัวช่วยบอกถึงภาวะของการย่อยและการดูดซึมอาหารซึ่งเป็นต้นเหตุของหลายอาการในระบบทางเดินอาหาร เช่น อาหารไม่ย่อย ท้องอืด ท้องเฟ้อ เรอ
- เมื่อมีอาการผิดปกติในเนื้ออุจจาระ เช่น อุจจาระเป็นน้ำ เป็นก้อน หรืออุจจาระเป็นเลือด/มีมูกเลือด ทั้งนี้เพราะสามารถช่วยแพทย์ในการวินิจฉัยแยกโรคได้ เช่น โรคบิด โรคอาหารเป็นพิษ อหิวาตกโรค หรือโรคเกี่ยวกับระบบการย่อยอาหาร
- ตรวจหาตัวพยาธิหรือไข่พยาธิ เช่น พยาธิปากขอ พยาธิเส้นด้าย พยาธิใบไม้ตับ, กรณีแพทย์สงสัยว่าผู้ป่วยอาจมีพยาธิในระบบทางเดินอาหาร โดยเฉพาะในเด็ก, ผู้มีอาชีพกสิกรรม
- ต้องการหาชนิดของเชื้อโรคและ/หรือต้องการทราบถึงประสิทธิผลของยาต่างๆโดยเฉพาะยาปฏิชีวนะ, เมื่อผู้ป่วยมีการติดเชื้อในระบบทางเดินอาหาร เช่น แบคทีเรีย โรคติดเชื้อไวรัส โรคเชื้อรา หรือโรคติดเชื้อปรสิต
- ตรวจหาภาวะมีเลือดออกในทางเดินอาหาร เช่น เมื่อผู้ป่วยมีโรคซีดโดยหาสาเหตุไม่ได้, หรือเป็นการคัดกรองหาแผลหรือโรคมะเร็งในระบบทางเดินอาหาร เช่น มะเร็งลำไส้ใหญ่
- ตรวจหาความผิดปกติของการย่อยอาหาร เพื่อวินิจฉัยหาสาเหตุของโรคที่เกี่ยวกับการย่อยและการดูดซึมอาหาร เช่น ภาวะขาดเอนไซม์แลคเตส ภาวะแพ้นมวัว อาการท้องเสียเรื้อรัง
ข้อห้ามการตรวจอุจจาระมีอะไรบ้าง?
ไม่มีข้อห้ามในการตรวจอุจจาระเพราะเป็นการตรวจที่ง่าย, ไม่ต้องเตรียมตัวล่วงหน้า, ไม่เจ็บตัว, ค่าใช้จ่ายไม่แพง, ในประเทศเรา การตรวจ/ค่าตรวจจะอยู่ในทุกระบบประกันสุขภาพ
การตรวจอุจจาระตรวจอะไรบ้าง?
ทั่วไป การตรวจอุจจาระแบ่งเป็น 2 การตรวจ คือ การตรวจพื้นฐาน, และการตรวจเฉพาะเจาะจง
ก. การตรวจพื้นฐาน: เป็นการตรวจในเบื้องต้น เป็นการตรวจที่ไม่ต้องมีการเตรียมตัวล่วงหน้า เป็นการตรวจสุขภาพทั่วไปเพื่อคัดกรองโรคในระบบทางเดินอาหาร, การตรวจจะโดยการสังเกตด้วยตาเปล่า, ขยายดูด้วยกล้องจุลทรรศน์, และการตรวจทางห้องปฏิบัติการอื่นๆเพิ่มเติมบ้างด้วยเทคนิคง่าย ไม่ซับซ้อนยุ่งยาก ซึ่งเป็นการตรวจคัดกรองเบื้องต้น ที่สามารถให้การตรวจได้ในทุกสถานพยาบาล
การตรวจอุจจาระพื้นฐาน: เช่น
- การดูลักษณะภายนอกของอุจจาระ เช่น แข็ง นุ่ม เป็นน้ำ มีมูก มีเลือดปน เป็นเม็ดกระสุน แบนเล็กเหมือนริบบิน หรือเป็นฟองไขมัน ดูสีของอุจจาระ เช่น สีน้ำตาลปกติ, ดำเหมือนยางมะตอย, หรือซีดออกขาว
- การส่องกล้องตรวจ: เช่น ดูเม็ดเลือดขาว เม็ดเลือดแดง ตัวพยาธิ และไข่พยาธิ
- บางโรงพยาบาล อาจให้บริการพิเศษโดยตรวจเพิ่มเติม เช่น การตรวจค่าความเป็นกรดหรือด่างของอุจจาระ (ค่า pH, Potential of hydrogen), และตรวจพื้นฐานดูภาวะมีเลือดปนในอุจจาระ (Stool for blood)
ข. การตรวจเฉพาะเจาะจง (Comprehensive digestive stool analysis เรียกย่อว่า CDSA): เช่น
- ตรวจเลือดในอุจจาระขั้นละเอียด (Stool guaiac test) เพื่อช่วยคัดกรองมะเร็งลำไส้ใหญ่
- การตรวจหาเชื้อ และ/หรือร่วมกับ การตรวจเพาะเชื้อต่างๆ เพื่อให้รู้ว่าการติดเชื้อในระบบทางเดินอาหารเกิดจากการติดเชื้อชนิดใด เช่น เชื้อโรคไทฟอยด์ หรือ เชื้อโรคบิด
- ตรวจหาน้ำย่อย หรือเอนไซม์ในการย่อยอาหารชนิดต่างๆ เพื่อดูว่าการย่อยอาหารผิดปกติจากเอนไซม์ตัวใด เช่น เอนไซม์ Chymotrypsin ของตับอ่อนที่จะช่วยวินิจฉัยโรคตับอ่อนอักเสบเรื้อรังได้
- ตรวจหาปริมาณไขมันทั้งหมดในอุจจาระ: เช่น เพื่อช่วยวินิจฉัยภาวะความผิดปกติในการดูดซึมอาหาร (Malabsorption syndrome) เป็นต้น
ทั้งนี้ การตรวจเฉพาะเจาะจงเหล่านี้ บางการตรวจต้องมีการเตรียมตัว จึงแตกต่างกันในแต่ละการตรวจ, ดังนั้น แพทย์ พยาบาลที่ดูแลรักษาผู้ป่วยจะเป็นผู้อธิบายการเตรียมตัวนั้นๆให้ผู้ป่วยทราบ, ทั่วไป การเตรียมตัวจะสัมพันธ์กับ อาหารและยา เช่น การหยุดกินยาบางชนิด หรือการหยุดกินเนื้อสัตว์ หรือพืชที่มีธาตุเหล็กสูง (มีสีเขียวเข็ม หรือสีออกแดง แสด หรือเหลือง) ประมาณ 3 วันก่อนการตรวจในการตรวจหาเลือดในอุจจาระด้วยวิธี Stool guaiac test เป็นต้น
เตรียมตัวอย่างไรในการตรวจอุจจาระ?
การตรวจอุจจาระโดยทั่วไปเป็นการตรวจพื้นฐาน: คือ ตรวจดูลักษณะภายนอกของอุจจาระ, ตรวจอุจจาระด้วยกล้องจุลทรรศน์, และ/หรือมีการตรวจทางห้องปฏิบัติการชนิดไม่ยุ่งยาก ดังได้กล่าว แล้วใน’หัวข้อ การตรวจอุจจาระตรวจอะไรบ้าง’ ดังนั้นจึงไม่ต้องเตรียมตัวล่วงหน้า เพียงเก็บอุจจาระที่ถ่ายตามปกติใส่ภาชนะที่ห้องปฏิบัติการมอบให้, และนำส่งฯห้องตรวจ/ห้องปฏิบัติการ
ส่วนการตรวจเฉพาะเจาะจง: อาจมีการเตรียมตัวบ้างในเรื่องที่เกี่ยวกับการกินอาหาร หรือ การกินยาต่างๆ ที่อาจรบกวนส่งผลให้ผลตรวจผิดพลาดได้ ดังนั้น เพียงหยุดยา หรืองดอาหารตามแพทย์ พยาบาลแนะนำ, ส่วนขั้นตอนอื่นๆเช่นเดียวกับการตรวจอุจจาระพื้นฐาน
มีขั้นตอนการตรวจอุจจาระอย่างไร?
ขั้นตอนการตรวจอุจจาระเป็นขั้นตอนง่ายๆ ถ้าต้องมีการงดอาหารและ/หรือยาบางประเภทก็ให้ปฏิบัติตามที่แพทย์พยาบาลแนะนำเท่านั้น, นอกจากนั้นคือการเก็บอุจจาระที่ถ่ายตามปกติของ เราใส่ในภาชนะที่โรงพยาบาลให้ไว้ แล้วนำส่งห้องตรวจ/ห้องปฏิบัติการภายใน 24 ชั่วโมงหลังถ่าย อุจจาระ
การเก็บอุจจาระ ให้ปฏิบัติตามคำแนะนำของแพทย์ พยาบาล หรือเจ้าหน้าที่ห้องตรวจ, ซึ่งโดยทั่วไปเทคนิคในการเก็บอุจจาระ: เช่น
- เตรียมวัสดุที่จะป้ายเก็บอุจจาระ ซึ่งควรเป็นไม้แผ่นเล็กๆ ลักษณะคล้ายไม้พาย เช่น ไม้ไอศกรีม หรือช้อนพลาสติกที่ใช้ครั้งเดียวแล้วทิ้ง
- ปัสสาวะก่อนให้เรียบร้อย เพื่อป้องกันการปนเปื้อนของปัสสาวะซึ่งจะส่งผลให้การตรวจ อุจจาระผิดพลาดได้
- ไม่เก็บอุจจาระจากโถส้วม เพราะอุจจาระอาจปนน้ำในโถส้วม ที่อาจส่งผลให้ ผลการตรวจผิดพลาดได้
- ใส่ถุงมือยาง ไม่จำเป็นต้องเป็นชนิดปลอดเชื้อ เพื่อป้องกันอุจจาระเปื้อนมือ
- ถ่ายอุจจาระลงในแผ่น/ถาดพลาสติก หรือถุงพลาสติกที่ปากถุงกว้าง แห้งสะอาด
- ใช้ไม้ป้ายอุจจาระ แล้วเก็บอุจจาระใส่ภาชนะที่ห้องปฏิบัติการหรือเจ้าหน้าที่ให้มา ซึ่งอาจเป็นกล่องหรือขวดที่มีฝาปิดมิดชิด, กระจายการป้ายเก็บฯให้ทั่วก้อนอุจจาระทุกจุด โดยเฉพาะจุดผิดปกติ แต่ต้องไม่เลือกเฉพาะจุดที่ผิดปกติ เพื่อเพิ่มความแม่นยำในการตรวจ, รวมกันแล้วให้ได้ปริมาณอุจจาระประมาณ “นิ้วหัวแม่มือ” ถ้าอุจจาระเป็นน้ำหรือเป็นมูกเลือดก็ให้เก็บส่วนที่ผิดปกตินั้นๆมาด้วย
ทั้งนี้ การเก็บปริมาณอุจจาระเมื่อเป็นการตรวจเฉพาะเจาะจง ให้เก็บในปริมาณตามคำแนะนำของแพทย์ พยาบาล หรือเจ้าหน้าที่ห้องตรวจ
- ในขณะป้ายเก็บอุจจาระ ควรระวังไม่ให้มือสัมผัสกับอุจจาระ
- ปิดฝาที่เก็บอุจจาระให้สนิท, เช็ดภาชนะบรรจุอุจจาระให้สะอาด
- ถอดถุงมือ ทิ้งถุงมือ, และไม้/ช้อนป้ายอุจจาระในถุงพลาสติก, ปิดปากถุงให้แน่น, นำทิ้งในถังขยะสำหรับขยะติดเชื้อ, หลังจากนั้น ล้างมือให้สะอาดด้วยสบู่และน้ำสะอาด
- ติดชื่อนามสกุล วันที่ และเลขประจำตัวโรงพยาบาลให้ถูกต้องชัดเจนบนภาชนะเก็บ อุจจาระ
- เก็บภาชนะใส่อุจจาระในถุงพลาสติก 2 ชั้น, ปิดปากถุงทีละชั้นให้แน่นเรียบร้อย
- นำส่งเจ้าหน้าที่ห้องตรวจ ทั้งนี้อาจเก็บอุจจาระไว้ในตู้เย็นได้นาน 24 ชั่วโมงโดยให้เก็บไว้ในช่องที่ไม่ใช่ช่องเก็บอาหาร น้ำดื่ม และช่องแช่แข็ง
ได้ผลตรวจเมื่อไร?
เนื่องจากเป็นการตรวจที่ไม่ยุ่งยาก ทั่วไป การตรวจอุจจาระพื้นฐานจึงมักทราบผลภายใน 24 ชั่วโมง, แต่ถ้าเป็นโรงพยาบาลที่มีจำนวนผู้ป่วยต่อเจ้าหน้าที่ห้องตรวจที่น้อย อาจทราบผลตรวจได้ภายในระยะเวลา 2 - 3 ชั่วโมง
แปลผลตรวจอุจจาระอย่างไร?
เมื่อห้องปฏิบัติการตรวจอุจจาระแล้ว จะส่งผลตรวจให้แพทย์ และ/หรือให้ผู้ป่วยเพื่อนำไปให้แพทย์/พยาบาล หรือแจ้งผลผ่านระบบคอมพิวเตอร์โรงพยาบาล, ทั้งนี้ขึ้นกับระบบของแต่ละโรงพยาบาล, ซึ่งแพทย์/พยาบาลที่ดูแลรักษาผู้ป่วยจะเป็นผู้แปลผลให้ผู้ป่วยทราบ
อย่างไรก็ตาม ผู้ป่วยสามารถทราบผลตรวจได้เองว่า การตรวจปกติหรือผิดปกติทั้งนี้เพราะ ทั่วไปในใบรายงานผลตรวจของห้องปฏิบัติการ จะมีค่าตรวจปกติกำกับไว้ให้ด้วยเสมอ
แพทย์จะแปลผลการตรวจจากห้องปฏิบัติการ: โดย
- ดูรายงานลักษณะภายนอกของอุจจาระ เช่น
- เป็นก้อนแข็งปกติ เป็นน้ำ เป็นเส้นบาง
- มีมูก เลือด ปนหรือไม่
- มีสีเป็นอย่างไร เช่น น้ำตาลเข้มปกติ หรือขาวซีด
- ดูจากผลการตรวจด้วยกล้องจุลทรรศ์/รายงานผลจากห้องปฏิบัติการ: การมีเม็ดเลือดขาวจะช่วยการวินิจฉัยถึงการติดเชื้อ
- ดูจากเม็ดเลือดแดงและการตรวจเลือดปนในอุจจาระที่จะช่วยบอกภาวะมีเลือดออกในทางเดินอาหาร
- ค่า pH ของอุจจาระปกติจะเป็นด่าง, ถ้าค่าเป็นกรดจะช่วยบอกถึงมีระบบการย่อยอาหาร ที่ผิดปกติ
- การตรวจพบพยาธิหรือไข่พยาธิจะช่วยบอกถึงการมีโรคติดเชื้อปรสิต
การเพาะเชื้อจะช่วยบอกถึงชนิดของการติดเชื้อในระบบทางเดินอาหาร
การตรวจอุจจาระมีผลข้างเคียงไหม?
ดังกล่าวแล้วว่า การตรวจอุจจาระเป็นการตรวจที่ง่ายไม่เจ็บตัว เพียงเก็บอุจจาระที่ถ่ายออก มาตามธรรมชาติของเรา, ใส่ภาชนะแล้วนำมาส่งยังห้องตรวจหรือห้องปฏิบัติการเท่านั้น, ดังนั้นจึงไม่มีอันตราย ไม่มีผลข้างเคียงใดๆทั้งสิ้น, ตรวจได้ในทุกเพศทุกวัยตั้งแต่เด็กแรกเกิดไปจนถึงผู้สูงอายุ
หลังตรวจต้องปฏิบัติตนอย่างไร?
ดังกล่าวแล้วว่า การตรวจอุจจาระ คือ การเก็บอุจจาระที่ถ่ายตามปกติ ใส่ภาชนะและนำส่งห้องปฏิบัติการเท่านั้น, ดังนั้นจึงใช้ชีวิตได้ตามปกติทั้งก่อนตรวจนและหลังตรวจฯ, ไม่มีข้อต้องระวังหรือข้อจำกัดใดทั้งสิ้นในการใช้ชีวิตประจำวัน